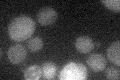

View description
Plasma membrane ATP-binding cassette (ABC) transporter, multidrug transporter involved in multidrug resistance and resistance to singlet oxygen species
Localization:
Intensity:
Fold change:
Significance:
-
C’ GFP library in SD
below threshold15.52 -
N' NOP1pr-GFP in SD

cell periphery68.8719 -
N' TEF2pr-mCherry in SD

cell periphery,vacuole125.757 -
N' NATIVEpr-GFP in SD

below threshold20.7066 -
N' TEF2pr-VC and Cyto-VN in SD

cell periphery,punctate36.621 -
C’ GFP library in SD+DTT

cytosol17.691.13No -
C’ GFP library in SD+H2O2

cytosol15.20.97No -
C’ GFP library in Starvation Media

cytosol14.60.94No -
C’ GFP library on the background of Pup2-DaMP

below threshold -
C’ GFP library on the background of CCT mutant

below threshold14.53010.935749No
